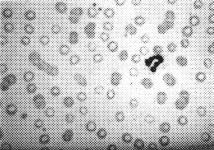
���t�w��������

| 白血球数 | 2.33 | ×10^3/mm3 | 赤血球数 | 2.34 | ×10^6/mm3 |
| 桿状球 | 11 | % | Hb | 6.9 | g/dL |
| 分葉球 | 74 | % | Ht | 22.2 | % |
| リンパ球 | 11 | % | 血小板数 | 210 | ×10^3/mm3 |
| 異型リンパ球 | 1 | % | Ret | 28 | % |
| 単球 | 3 | % | 赤血球大小不同 | ||
| 低色素性赤血球 | |||||
| 連銭形成 | |||||

双方の検査成績から多発性骨髄腫を疑い骨髄穿刺を実施いたしました。
| 血液学的検査成績では貧血と抹梢血液像では赤血球に強い連銭形成が見られます。 双方の検査成績から多発性骨髄腫を疑い骨髄穿刺を実施いたしました。 | ||||||||||||||||||||||||||||||||||||||||||||||||